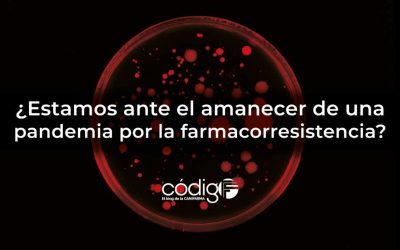
¿Estamos ante el amanecer de una pandemia por la farmacorresistencia?

MPOWER: La iniciativa de la OMS para acabar con la pandemia del tabaquismo
Ninguna medida será eficaz para combatir este mortal hábito sin la participación decidida de los líderes políticos y las autoridades hacendarias y sanitarias de cada naciónCada día que pasa lo tenemos más claro: el consumo de tabaco es un factor de riesgo para seis de...
Una nueva estrategia para combatir al vector de la malaria consigue reducir un 26 % la incidencia de infecciones, matando paralelamente a los mosquitos
La administración masiva de ivermectina se propone como una intervención integral de salud pública contra la malaria y múltiples enfermedades tropicales desatendidas, combinándose con la distribución masiva de otros medicamentos o intervencionesEl pasado 23 de julio...
¿Estamos ante el amanecer de una pandemia por la farmacorresistencia?
Aunque alarmante, no podemos calificar de banal el título de esta nota. Como punto de partida para tratar de responder cabalmente a esta inquietante pregunta, les recordamos que la Organización Mundial de la Salud (OMS) asegura que la resistencia a los antimicrobianos...
Prótesis conectadas a músculos y nervios humanos, que funcionan e interactúan de manera orgánica como los miembros perdidos
Aunque la narrativa parece escrita por un equipo de escritores altamente creativos para un guión cinematográfico de lucha contra la adversidad y superación personal, la historia de un chico que a los 17 años perdió ambas piernas como consecuencia del congelamiento...
Cirugías robóticas al 100%
Un robot entrenado previamente con videos de cirugías realizó con absoluta precisión la extirpación de vesículas biliares en modelos animales, sin intervención humanaEn múltiples ocasiones hemos escrito en este medio la forma en la que estamos viviendo –entre...
Una terapia génica experimental repara la mutación del gen OTOF, devolviendo la audición a 10 pacientes
El éxito del protocolo se suma a otros logros obtenidos previamente en los EE. UU. y China, dando esperanza a quienes nacen con esta condición El pasado 2 de julio se publicó en Nature Medicine un estudio con el título “AAV gene therapy for autosomal recessive...